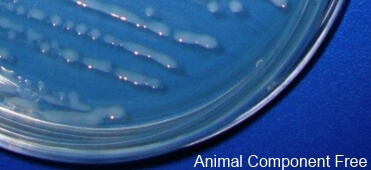

| Altergon Injectable Hyaluronate | ||
| Ultrapure | Plus PH | |
|
Certification
|
Certification
|
|
|
Endotoxins ≤5 EU/GRAM) ≤0.005 I.U/mg |
Endotoxins ≤500 EU/GRAM) ≤0.5 I.U/mg |
|
|
Molecular Weight range: 40-3,000 kDa |
Molecular Weight range: 40-3,000 kDa |
|
|
Intrinsic Viscosity: 0.2-3.2 m3/Kg |
Intrinsic Viscosity: 0.2-3.2 m3/Kg |
|
|
Intended use:
|
Intended use:
|
|

The following examples reports part of the specifications of Ultra Pure Hyaluronate
We have other products which comply with many important Pharmacopoeias. For further details please contact us
| Characteristic | European Pharmacopoeia Requirements | Altergon Ultrapure Hyaluronate |
| Nucleic acids Absorbance 260 nm (0.33 % solution, dried) | ≤ 0.5 | ≤ 0.02 |
| Proteins | ≤ 0.1 % | ≤ 0.03 % |
| Iron | ≤ 80 ppm | ≤ 10 ppm |
| Loss on drying | ≤ 20.0 % | ≤ 15.0 % |
| Microbial contamination TAMC (Total Aerobic Microbial Count) TYMC (Total Yeast and Mould Count) |
≤ 100 CFU/g Not reported |
≤ 10 CFU/g ≤ 10 CFU/g |
| Bacterial endotoxins (Gel Clot) | < 0.05 I.U./mg | < 0.005 I.U./mg |
| Residual of Ethanol (other residual solvents are excluded by the manufacturing process) | < 0.5% | < 0.1% |
| Intrinsic viscosity at 25 C° | Not reported | 0.2- 3.2 m3/Kg |
A dedicated Plant, specifically designed to optimize batch size, quality and purity intended to be used in M.D. production, GMP managed under ISO 9001 system.
| ALTERGON MEDICAL GRADE HYALURONATE | ||
| Plus MD | ||
|
Certification
|
||
|
Endotoxins ≤500 EU/GRAM) ≤0.5 I.U/mg |
||
|
Molecular Weight range: 200-2,000 kDa |
||
|
Intrinsic Viscosity: 0.5-2.5 m3/Kg |
||
|
Intended use: Medical Device(Customer Specifications) |
||